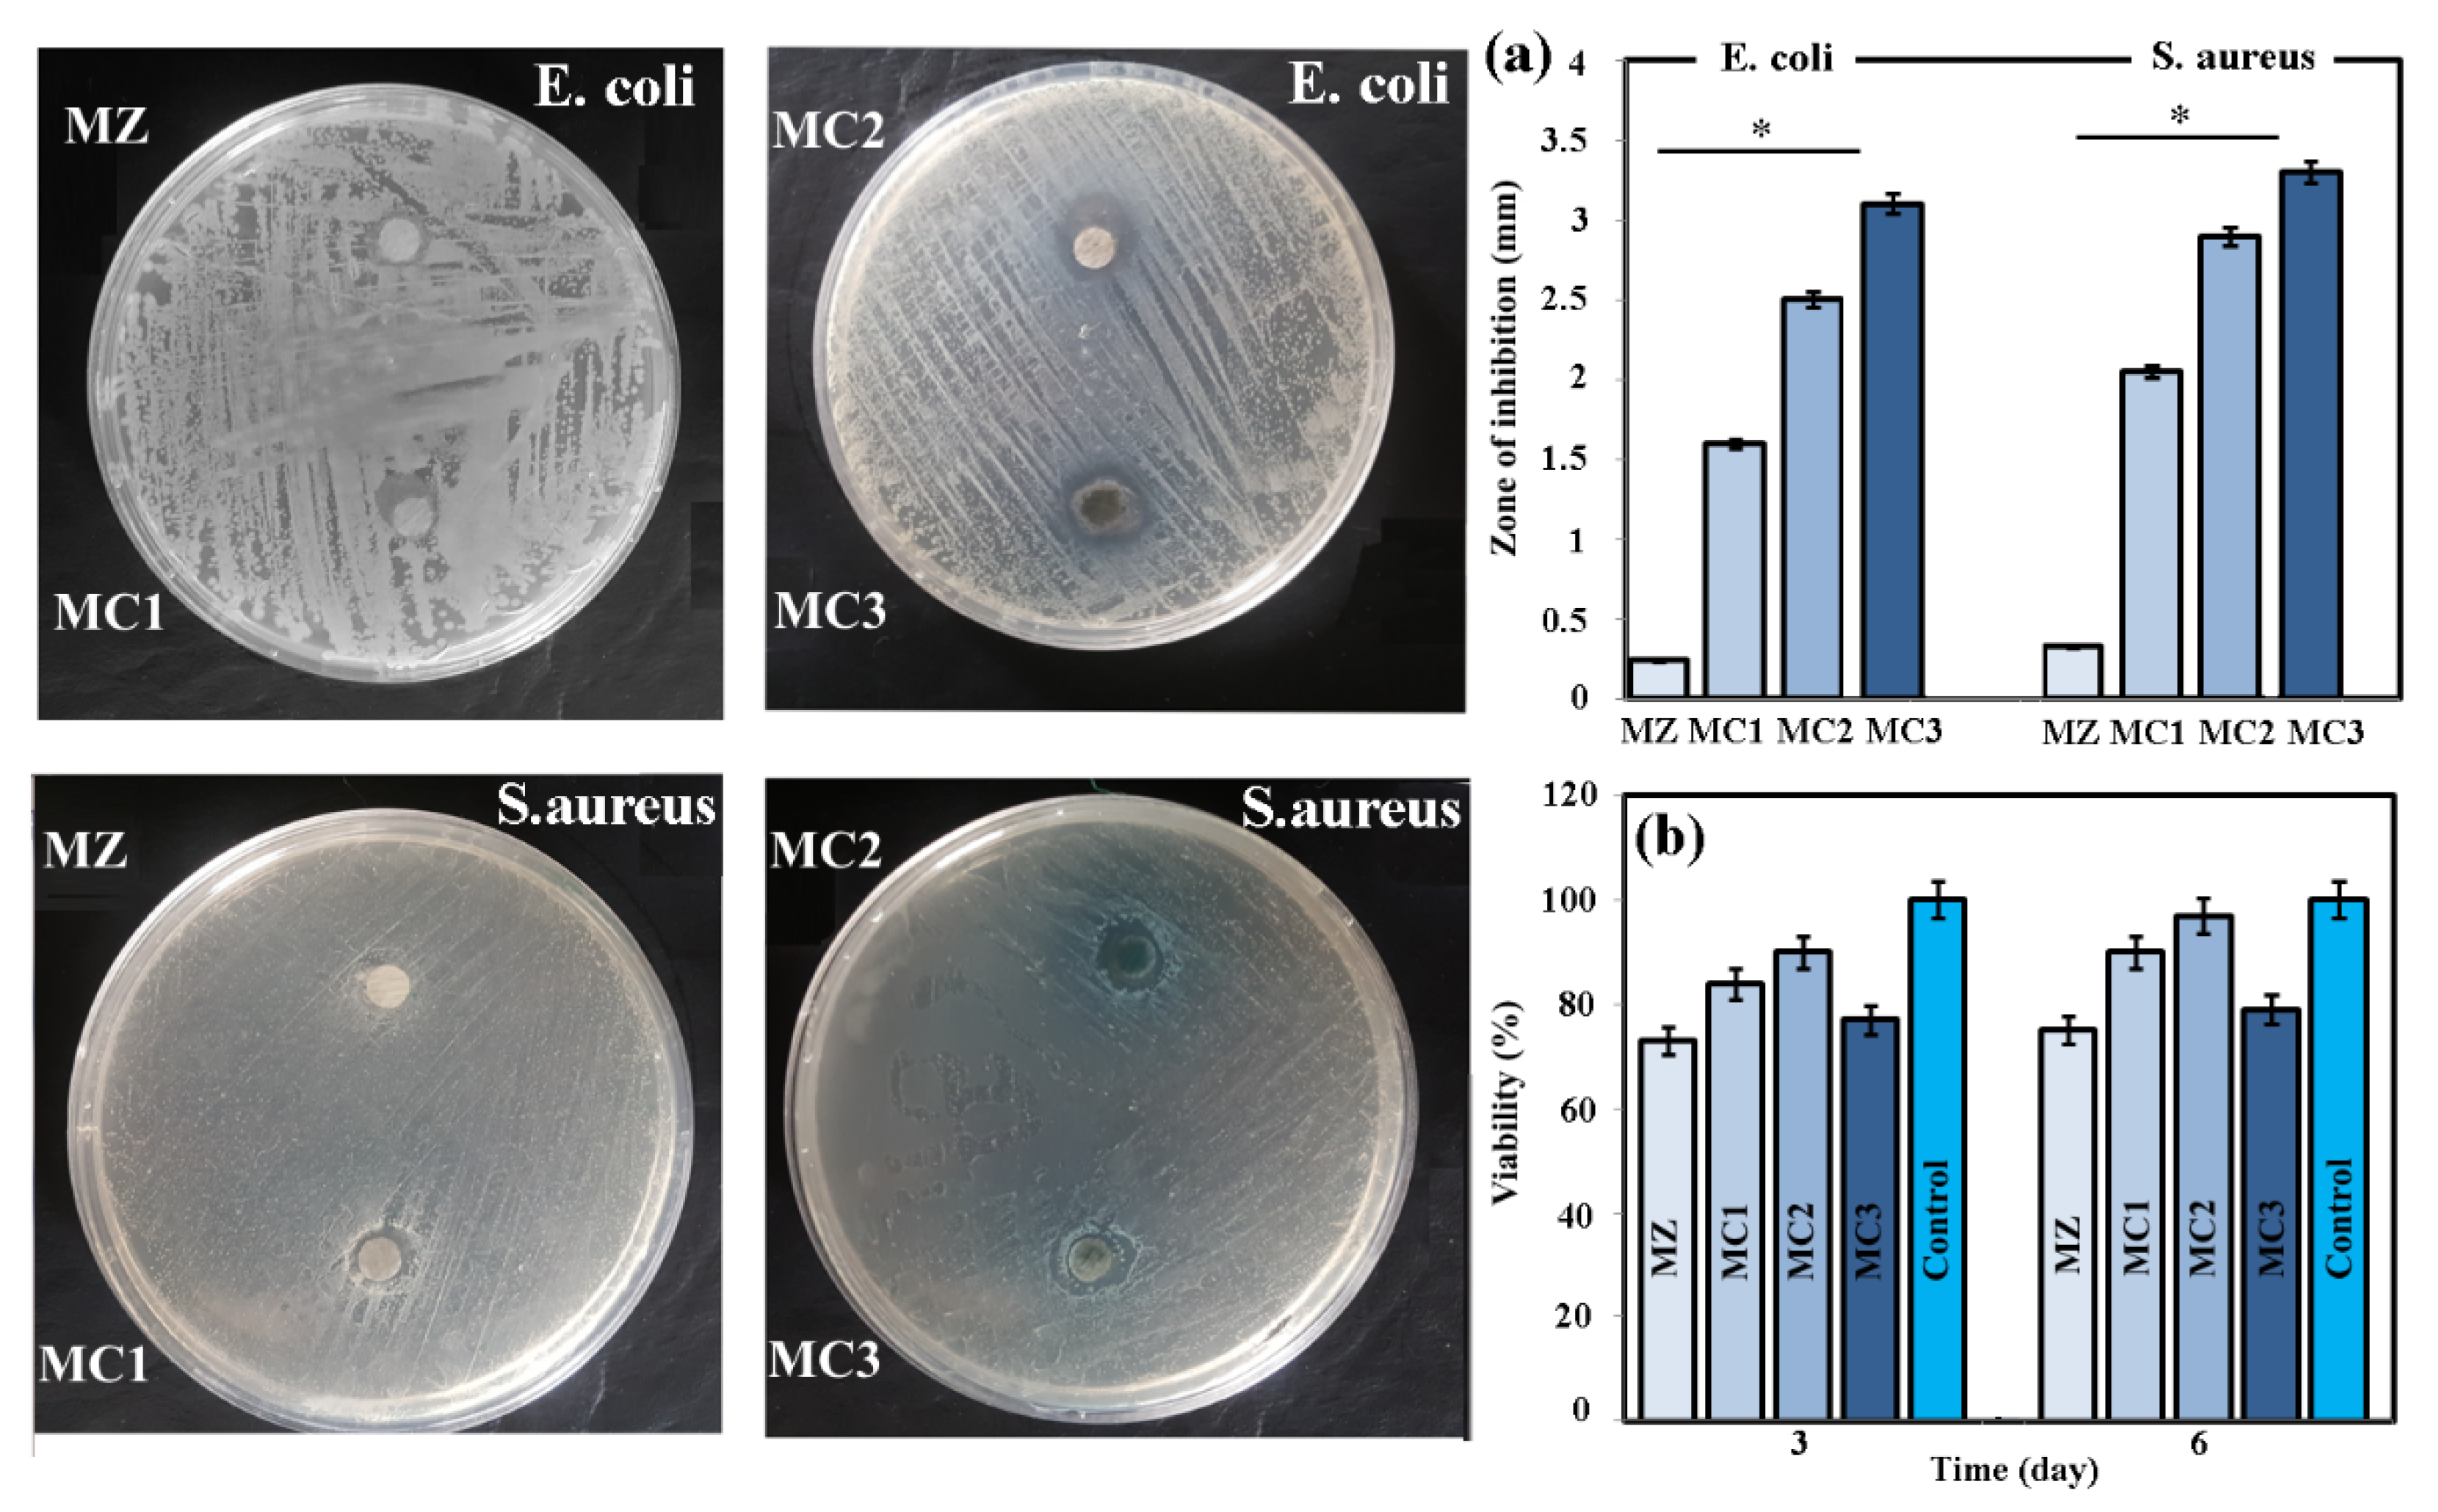
Coatings 12 01589 g011

Carbon Nanotube (CNT) Encapsulated Magnesium-Based Nanocomposites to Improve Mechanical, Degradation and Antibacterial Performances for Biomedical Device Applications
Abstract
1. Introduction
2. Materials and Methods
2.1. Raw Materials
2.2. Microstructure and Mechanical Properties
2.3. Degradation Behavior
2.4. Antibacterial Evaluation
2.5. Biocompatibility Assessment
2.6. Statistical Analysis
3. Results and Discussions
3.1. Microstructure
3.2. Mechanical Properties
3.3. Assessment of Degradation Behavior
- I.
- Cathodic decomposition of water,
- II.
- Anodic dissolution of α-Mg
- III.
- Creation of a hydroxide layer
3.4. Biological Properties
3.4.1. Antibacterial Evaluation
3.4.2. Cellular Compatibility
4. Conclusions
Author Contributions
Funding
Institutional Review Board Statement
Informed Consent Statement
Data Availability Statement
Conflicts of Interest
References
- Zheng, Y.F.; Gu, X.N.; Witte, F. Biodegradable Metals. Mater. Sci. Eng. R Rep. 2014, 77, 1–34. [Google Scholar] [CrossRef]
- Khorashadizade, F.; Abazari, S.; Rajabi, M.; Bakhsheshi-Rad, H.R.; Ismail, A.F.; Sharif, S.; Ramakrishna, S.; Berto, F. Overview of Magnesium-Ceramic Composites: Mechanical, Corrosion and Biological Properties. J. Mater. Res. Technol. 2021, 15, 6034–6066. [Google Scholar] [CrossRef]
- Kamrani, S.; Fleck, C. Biodegradable Magnesium Alloys as Temporary Orthopaedic Implants: A Review. BioMetals 2019, 32, 185–193. [Google Scholar] [CrossRef] [PubMed]
- Amukarimi, S.; Mozafari, M. Biodegradable Magnesium Biomaterials—Road to the Clinic. Bioengineering 2022, 9, 107. [Google Scholar] [CrossRef] [PubMed]
- Liu, C.; Ren, Z.; Xu, Y.; Pang, S.; Zhao, X.; Zhao, Y. Biodegradable Magnesium Alloys Developed as Bone Repair Materials: A Review. Scanning 2018, 2018, 9216314. [Google Scholar] [CrossRef]
- Ali, M.; Hussein, M.A.; Al-Aqeeli, N. Magnesium-Based Composites and Alloys for Medical Applications: A Review of Mechanical and Corrosion Properties. J. Alloys Compd. 2019, 792, 1162–1190. [Google Scholar] [CrossRef]
- Saberi, A.; Bakhsheshi-Rad, H.R.; Karamian, E.; Kasiri-Asgarani, M.; Ghomi, H. Magnesium-Graphene Nano-Platelet Composites: Corrosion Behavior, Mechanical and Biological Properties. J. Alloys Compd. 2020, 821, 153379. [Google Scholar] [CrossRef]
- Saberi, A.; Bakhsheshi-Rad, H.R.; Karamian, E.; Kasiri-Asgarani, M.; Ghomi, H.; Omidi, M.; Abazari, S.; Ismail, A.F.; Sharif, S.; Berto, F. Synthesis and Characterization of Hot Extruded Magnesium-Zinc Nano-Composites Containing Low Content of Graphene Oxide for Implant Applications. Phys. Mesomech. 2021, 24, 486–502. [Google Scholar] [CrossRef]
- Wei, X.; Liu, P.; Ma, S.; Li, Z.; Peng, X.; Deng, R.; Zhao, Q. Improvement on Corrosion Resistance and Biocompability of ZK60 Magnesium Alloy by Carboxyl Ion Implantation. Corros. Sci. 2020, 173, 108729. [Google Scholar] [CrossRef]
- Koç, E.; Kannan, M.B.; Ünal, M.; Candan, E. Influence of Zinc on the Microstructure, Mechanical Properties and in Vitro Corrosion Behavior of Magnesium–Zinc Binary Alloys. J. Alloys Compd. 2015, 648, 291–296. [Google Scholar] [CrossRef]
- Li, Y.; Liu, L.; Wan, P.; Zhai, Z.; Mao, Z.; Ouyang, Z.; Yu, D.; Sun, Q.; Tan, L.; Ren, L.; et al. Biodegradable Mg-Cu Alloy Implants with Antibacterial Activity for the Treatment of Osteomyelitis: In Vitro and in Vivo Evaluations. Biomaterials 2016, 106, 250–263. [Google Scholar] [CrossRef]
- Shuai, C.; Guo, W.; Wu, P.; Yang, W.; Hu, S.; Xia, Y.; Feng, P. A Graphene Oxide-Ag Co-Dispersing Nanosystem: Dual Synergistic Effects on Antibacterial Activities and Mechanical Properties of Polymer Scaffolds. Chem. Eng. J. 2018, 347, 322–333. [Google Scholar] [CrossRef]
- Nie, K.B.; Wang, X.J.; Deng, K.K.; Hu, X.S.; Wu, K. Magnesium Matrix Composite Reinforced by Nanoparticles—A Review. J. Magnes. Alloys 2021, 9, 57–77. [Google Scholar] [CrossRef]
- Răducanu, D.; Cojocaru, V.D.; Șerban, N.; Trişcă-Rusu, C.; Necula, M.G.; Mudrac, R.A.; Dan, I.; Nocivin, A.; Cinca, I. Processing and Properties of a New Biodegradable Mg−Zn−Ca−Zr Alloy. Materwiss. Werksttech. 2019, 50, 553–564. [Google Scholar] [CrossRef]
- Jiang, W.; Yu, W. In Vitro Degradation Behavior, Mechanical Properties, and Cytocompatibility of Biodegradable Mg-1Zn-XSn Alloys. Crystals 2022, 12, 1219. [Google Scholar] [CrossRef]
- Roohani, N.; Hurrell, R.; Kelishadi, R.; Schulin, R. Zinc and Its Importance for Human Health: An Integrative Review. J. Res. Med. Sci. 2013, 18, 144–157. [Google Scholar]
- Ding, Y.; Wen, C.; Hodgson, P.; Li, Y. Effects of Alloying Elements on the Corrosion Behavior and Biocompatibility of Biodegradable Magnesium Alloys: A Review. J. Mater. Chem. B 2014, 2, 1912–1933. [Google Scholar] [CrossRef]
- Drelich, A.J.; Zhao, S.; Guillory, R.J.; Drelich, J.W.; Goldman, J. Long-Term Surveillance of Zinc Implant in Murine Artery: Surprisingly Steady Biocorrosion Rate. Acta Biomater. 2017, 58, 539–549. [Google Scholar] [CrossRef]
- Tsai, M.-H.; Chen, M.-S.; Lin, L.-H.; Lin, M.-H.; Wu, C.-Z.; Ou, K.-L.; Yu, C.-H. Effect of Heat Treatment on the Microstructures and Damping Properties of Biomedical Mg–Zr Alloy. J. Alloys Compd. 2011, 509, 813–819. [Google Scholar] [CrossRef]
- Istrate, B.; Munteanu, C.; Geanta, V.; Baltatu, S.; Focsaneanu, S.; Earar, K. Microstructural Analysis of Biodegradable Mg-0.9Ca-1.2Zr Alloy. IOP Conference Series: Materials Science and Engineering. In Proceedings of the 7th International Conference on Advanced Concepts in Mechanical Engineering, Iasi, Romania, 9–10 June 2016; Volume 147, p. 012033. [Google Scholar] [CrossRef]
- Gu, X.; Zheng, Y.; Cheng, Y.; Zhong, S.; Xi, T. In Vitro Corrosion and Biocompatibility of Binary Magnesium Alloys. Biomaterials 2009, 30, 484–498. [Google Scholar] [CrossRef]
- Paramsothy, M.; Chan, J.; Kwok, R.; Gupta, M. Addition of CNTs to Enhance Tensile/Compressive Response of Magnesium Alloy ZK60A. Compos. Part A Appl. Sci. Manuf. 2011, 42, 180–188. [Google Scholar] [CrossRef]
- Ding, Y.; Xu, J.; Hu, J.; Gao, Q.; Guo, X.; Zhang, R.; An, L. High Performance Carbon Nanotube-Reinforced Magnesium Nanocomposite. Mater. Sci. Eng. A 2020, 771, 138575. [Google Scholar] [CrossRef]
- Radhamani, A.V.; Lau, H.C.; Ramakrishna, S. CNT-Reinforced Metal and Steel Nanocomposites: A Comprehensive Assessment of Progress and Future Directions. Compos. Part A Appl. Sci. Manuf. 2018, 114, 170–187. [Google Scholar] [CrossRef]
- Hou, J.; Du, W.; Wang, Z.; Li, S.; Liu, K.; Du, X. Combination of Enhanced Thermal Conductivity and Strength of MWCNTs Reinforced Mg-6Zn Matrix Composite. J. Alloys Compd. 2020, 838, 155573. [Google Scholar] [CrossRef]
- Abazari, S.; Shamsipur, A.; Bakhsheshi-Rad, H.R.; Berto, F. Functionalized Carbon Nanotube-Encapsulated Magnesium-Based Nanocomposites with Outstanding Mechanical and Biological Properties as Load-Bearing Bone Implants. Mater. Des. 2022, 213, 110354. [Google Scholar] [CrossRef]
- Say, Y.; Guler, O.; Dikici, B. Carbon Nanotube (CNT) Reinforced Magnesium Matrix Composites: The Effect of CNT Ratio on Their Mechanical Properties and Corrosion Resistance. Mater. Sci. Eng. A 2020, 798, 139636. [Google Scholar] [CrossRef]
- Rashad, M.; Pan, F.; Zhang, J.; Asif, M. Use of High Energy Ball Milling to Study the Role of Graphene Nanoplatelets and Carbon Nanotubes Reinforced Magnesium Alloyand Carbon Nanotubes Reinforced Magnesium Alloy. J. Alloys Compd. 2015, 646, 223–232. [Google Scholar] [CrossRef]
- Mindivan, H.; Efe, A.; Kosatepe, A.H.; Kayali, E.S. Fabrication and Characterization of Carbon Nanotube Reinforced Magnesium Matrix Composites. Appl. Surf. Sci. 2014, 318, 234–243. [Google Scholar] [CrossRef]
- Rashad, M.; Pan, F.; Tang, A.; Asif, M.; Aamir, M. Synergetic Effect of Graphene Nanoplatelets (GNPs) and Multi-Walled Carbon Nanotube (MW-CNTs) on Mechanical Properties of Pure Magnesium. J. Alloys Compd. 2014, 603, 111–118. [Google Scholar] [CrossRef]
- Paramsothy, M.; Tan, X.H.; Chan, J.; Kwok, R.; Gupta, M. Carbon Nanotube Addition to Concentrated Magnesium Alloy AZ81: Enhanced Ductility with Occasional Significant Increase in Strength. Mater. Des. 2013, 45, 15–23. [Google Scholar] [CrossRef]
- Habibi, M.K.; Paramsothy, M.; Hamouda, A.M.S.; Gupta, M. Enhanced Compressive Response of Hybrid Mg–CNT Nano-Composites. J. Mater. Sci. 2011, 46, 4588–4597. [Google Scholar] [CrossRef]
- Zhang, S.; Zhang, X.; Zhao, C.; Li, J.; Song, Y.; Xie, C.; Tao, H.; Zhang, Y.; He, Y.; Jiang, Y. Research on an Mg–Zn Alloy as a Degradable Biomaterial. Acta Biomater. 2010, 6, 626–640. [Google Scholar] [CrossRef] [PubMed]
- Singh, I.B.; Singh, M.; Das, S. A Comparative Corrosion Behavior of Mg, AZ31 and AZ91 Alloys in 3.5% NaCl Solution. J. Magnes. Alloys 2015, 3, 142–148. [Google Scholar] [CrossRef]
- Colindres, S.C.; Aguir, K.; Sodi, F.C.; Vargas, L.V.; Salazar, J.M.; Febles, V.G. Ozone Sensing Based on Palladium Decorated Carbon Nanotubes. Sensors 2014, 14, 6806–6818. [Google Scholar] [CrossRef] [PubMed]
- Rashad, M.; Pan, F.; Lin, D.; Asif, M. High Temperature Mechanical Behavior of AZ61 Magnesium Alloy Reinforced with Graphene Nanoplatelets. Mater. Des. 2016, 89, 1242–1250. [Google Scholar] [CrossRef]
- Razavi, M.; Fathi, M.; Savabi, O.; Vashaee, D.; Tayebi, L. Improvement of Biodegradability, Bioactivity, Mechanical Integrity and Cytocompatibility Behavior of Biodegradable Mg Based Orthopedic Implants Using Nanostructured Bredigite (Ca7MgSi4O16) Bioceramic Coated via ASD/EPD Technique. Ann. Biomed. Eng. 2014, 42, 2537–2550. [Google Scholar] [CrossRef]
- Xie, G.M.; Ma, Z.Y.; Geng, L.; Chen, R.S. Microstructural Evolution and Enhanced Superplasticity in Friction Stir Processed Mg-Zn-Y-Zr Alloy. J. Mater. Res. 2008, 23, 1207–1213. [Google Scholar] [CrossRef]
- Li, H.; Dai, X.; Zhao, L.; Li, B.; Wang, H.; Liang, C.; Fan, J. Microstructure and Properties of Carbon Nanotubes-Reinforced Magnesium Matrix Composites Fabricated via Novel in Situ Synthesis Process. J. Alloys Compd. 2019, 785, 146–155. [Google Scholar] [CrossRef]
- Shahin, M.; Wen, C.; Munir, K.; Li, Y. Mechanical and Corrosion Properties of Graphene Nanoplatelet–Reinforced Mg–Zr and Mg–Zr–Zn Matrix Nanocomposites for Biomedical Applications. J. Magnes. Alloys 2022, 10, 458–477. [Google Scholar] [CrossRef]
- Belyaeva, L.A.; Schneider, G.F. Wettability of Graphene. Surf. Sci. Rep. 2020, 75, 100482. [Google Scholar] [CrossRef]
- Sun, L.; Guo, J.; Chen, H.; Zhang, D.; Shang, L.; Zhang, B.; Zhao, Y. Tailoring Materials with Specific Wettability in Biomedical Engineering. Adv. Sci. 2021, 8, 2100126. [Google Scholar] [CrossRef] [PubMed]
- Razzaghi, M.; Kasiri-Asgarani, M.; Bakhsheshi-Rad, H.R.; Ghayour, H. In Vitro Degradation, Antibacterial Activity and Cytotoxicity of Mg-3Zn-XAg Nanocomposites Synthesized by Mechanical Alloying for Implant Applications. J. Mater. Eng. Perform. 2019, 28, 1441–1455. [Google Scholar] [CrossRef]
- Carneiro, Í.; Simões, S. Strengthening Mechanisms in Carbon Nanotubes Reinforced Metal Matrix Composites: A Review. Metals 2021, 11, 1613. [Google Scholar] [CrossRef]
- Yuan, Q.; Zeng, X.; Liu, Y.; Luo, L.; Wu, J.; Wang, Y.; Zhou, G. Microstructure and Mechanical Properties of AZ91 Alloy Reinforced by Carbon Nanotubes Coated with MgO. Carbon 2016, 96, 843–855. [Google Scholar] [CrossRef]
- Kondoh, K.; Fukuda, H.; Umeda, J.; Imai, H.; Fugetsu, B.; Endo, M. Microstructural and Mechanical Analysis of Carbon Nanotube Reinforced Magnesium Alloy Powder Composites. Mater. Sci. Eng. A 2010, 527, 4103–4108. [Google Scholar] [CrossRef]
- Tayebi, M.; Bizari, D.; Hassanzade, Z. Investigation of Mechanical Properties and Biocorrosion Behavior of in Situ and Ex Situ Mg Composite for Orthopedic Implants. Mater. Sci. Eng. C 2020, 113, 110974. [Google Scholar] [CrossRef]
- Ramezanzade, S.; Ebrahimi, G.R.; Torabi Parizi, M.; Ezatpour, H.R. Synergetic Effect of GNPs and MgOs on the Mechanical Properties of Mg–Sr–Ca Alloy. Mater. Sci. Eng. A 2019, 761, 138025. [Google Scholar] [CrossRef]
- Abazari, S.; Shamsipur, A.; Bakhsheshi-Rad, H.R.; Keshavarz, M.; Kehtari, M.; Ramakrishna, S.; Berto, F. MgO-Incorporated Carbon Nanotubes-Reinforced Mg-Based Composites to Improve Mechanical, Corrosion, and Biological Properties Targeting Biomedical Applications. J. Mater. Res. Technol. 2022, 20, 976–990. [Google Scholar] [CrossRef]
- Saberi, A.; Bakhsheshi-Rad, H.R.; Ismail, A.F.; Sharif, S.; Razzaghi, M.; Ramakrishna, S.; Berto, F. The Effect of Co-Encapsulated GO-Cu Nanofillers on Mechanical Properties, Cell Response, and Antibacterial Activities of Mg-Zn Composite. Metals 2022, 12, 207. [Google Scholar] [CrossRef]
- Lin, Z.; Sun, X.; Yang, H. The Role of Antibacterial Metallic Elements in Simultaneously Improving the Corrosion Resistance and Antibacterial Activity of Magnesium Alloys. Mater. Des. 2021, 198, 109350. [Google Scholar] [CrossRef]
- Abdel-Gawad, S.A.; Shoeib, M.A. Corrosion Studies and Microstructure of Mg−Zn−Ca Alloys for Biomedical Applications. Surf. Interfaces 2019, 14, 108–116. [Google Scholar] [CrossRef]
- Kerfahi, D.; Tripathi, B.M.; Singh, D.; Kim, H.; Lee, S.; Lee, J.; Adams, J.M. Effects of Functionalized and Raw Multi-Walled Carbon Nanotubes on Soil Bacterial Community Composition. PLoS ONE 2015, 10, e0123042. [Google Scholar] [CrossRef] [PubMed]
- Porter, A.E.; Gass, M.; Muller, K.; Skepper, J.N.; Midgley, P.A.; Welland, M. Direct Imaging of Single-Walled Carbon Nanotubes in Cells. Nat. Nanotechnol. 2007, 2, 713–717. [Google Scholar] [CrossRef] [PubMed]
- Khan, A.A.P.; Khan, A.; Rahman, M.M.; Asiri, A.M.; Oves, M. Lead Sensors Development and Antimicrobial Activities Based on Graphene Oxide/Carbon Nanotube/Poly(O-Toluidine) Nanocomposite. Int. J. Biol. Macromol. 2016, 89, 198–205. [Google Scholar] [CrossRef] [PubMed]
- Maksimova, Y.G. Microorganisms and Carbon Nanotubes: Interaction and Applications (Review). Appl. Biochem. Microbiol. 2019, 55, 1–12. [Google Scholar] [CrossRef]
- Shuai, C.; Liu, L.; Zhao, M.; Feng, P.; Yang, Y.; Guo, W.; Gao, C.; Yuan, F. Microstructure, Biodegradation, Antibacterial and Mechanical Properties of ZK60-Cu Alloys Prepared by Selective Laser Melting Technique. J. Mater. Sci. Technol. 2018, 34, 1944–1952. [Google Scholar] [CrossRef]
- Shuai, C.; Li, S.; Wang, G.; Yang, Y.; Peng, S.; Gao, C. Strong Corrosion Induced by Carbon Nanotubes to Accelerate Fe Biodegradation. Mater. Sci. Eng. C 2019, 104, 109935. [Google Scholar] [CrossRef]
- Baltatu, I.; Sandu, A.V.; Vlad, M.D.; Spataru, M.C.; Vizureanu, P.; Baltatu, M.S. Mechanical Characterization and In Vitro Assay of Biocompatible Titanium Alloys. Micromachines 2022, 13, 430. [Google Scholar] [CrossRef]
- Baltatu, M.S.; Vizureanu, P.; Sandu, A.V.; Florido-Suarez, N.; Saceleanu, M.V.; Mirza-Rosca, J.C. New Titanium Alloys, Promising Materials for Medical Devices. Materials 2021, 14, 5934. [Google Scholar] [CrossRef]

| Samples | Processing Route | Elongation(%) | Ultimate Compressive Strength, MPa | Hardness HV | Years | Ref. |
|---|---|---|---|---|---|---|
| MZ−3Zn | SPM + HTE | 12.1 ± 1.3 | 289.6 ± 13 | 66 ± 2 | 2022 | [26] |
| MZ−3Zn−0.2fCNT | SPM + HTE | 13.6 ± 1.5 | 368.2 ± 12 | 70 ± 2 | 2022 | [26] |
| MZ−3Zn−0.4fCNT | SPM + HTE | 15.7 ± 1.5 | 390 ± 15 | 74 ± 2.5 | 2022 | [26] |
| MZ−3Zn−0.8fCNT | SPM + HTE | 11.9 ± 1.3 | 320.2 ± 14 | 76 ± 3 | 2022 | [26] |
| AZ61 | PM | - | 135.7 | - | 2020 | [27] |
| AZ61−0.1CNT | PM | - | 127.2 | - | 2020 | [27] |
| AZ61−0.2CNT | PM | - | 146.8 | - | 2020 | [27] |
| AZ61−0.5CNT | PM | - | 168.4 | - | 2020 | [27] |
| AZ91 | PM | - | 141.2 | - | 2020 | [27] |
| AZ91−0.1CNT | PM | - | 132.3 | - | 2020 | [27] |
| AZ91−0.2CNT | PM | - | 145.6 | - | 2020 | [27] |
| AZ91−0.5CNT | PM | - | 153.5 | - | 2020 | [27] |
| AZ31 | PM + Extrusion | 14.5 ± 1.5 | 363 ± 3.5 | 58 ± 3.0 | 2015 | [28] |
| AZ31−0.3GNPs | PM + Extrusion | 21.7 ± 2.8 | 397 ± 5.3 | 71 ± 2.1 | 2015 | [28] |
| AZ31−0.3CNTs | PM + Extrusion | 13.3 ± 3.0 | 457 ± 6.0 | 78 ± 2.8 | 2015 | [28] |
| Mg−6Al−0.5CNT | MBM + CP + HTE | - | ~160 | ~40 | 2014 | [29] |
| Mg−6Al−1CNT | MBM + CP + HTE | - | ~140 | ~36 | 2014 | [29] |
| Mg−6Al−2CNT | MBM + CP + HTE | - | ~105 | ~34 | 2014 | [29] |
| Mg−6Al−4CNT | MBM + CP + HTE | - | ~75 | ~28 | 2014 | [29] |
| Mg−1Al | SPM + VS + HTE | 6.9 ± 0.5 | 377 ± 8 | 50 ± 4 | 2014 | [30] |
| Mg−1Al−0.6GNTs | SPM + VS + HTE | 4.0 ± 0.6 | 407 ± 3 | 63 ± 2 | 2014 | [30] |
| Mg−1Al−0.6CNTs | SPM + VS + HTE | 10 ± 0.3 | 425 ± 5 | 61 ± 5 | 2014 | [30] |
| Mg−1Al−0.6(1:5) (CNTs + GNPs) | SPM + VS + HTE | 16 ± 0.5 | 397 ± 3 | 56 ± 3 | 2014 | [30] |
| AZ81 | DMD + HTE | 7.9 | 487 ± 14 | 119 ± 2 | 2013 | [31] |
| AZ81−1.5CNTs | DMD + HTE | 12.9 | 488 ± 13 | 114 ± 8 | 2013 | [31] |
| ZK60A | DMD | 6.6 ± 0.6 | 522 ± 11 | 138 ± 7 | 2011 | [22] |
| ZK60A−1.0CNTs | DMD | 15.0 ± 0.7 | 547 ± 3 | 114 ± 6 | 2011 | [22] |
| Mg | PM-HTE | - | 239 ± 15 | 40 ± 2 | 2011 | [32] |
| Mg−0.5Al−0.18CNT | PM-HTE | - | 357 ± 13 | 50 ± 4 | 2011 | [32] |
| Mg−1Al−0.18CNT | PM-HTE | - | 421 ± 15 | 58 ± 3 | 2011 | [32] |
| Mg−1.5Al−0.18CNT | PM-HTE | - | 421 ± 11 | 60 ± 4 | 2011 | [32] |
| Solution | Ion Concentration (mmol/L) | |||||||
|---|---|---|---|---|---|---|---|---|
| Na+ | K+ | Ca2+ | Mg2+ | HCO3- | Cl− | HPO42− | SO42− | |
| Plasma | 142.0 | 5.0 | 2.5 | 1.5 | 27.0 | 103.0 | 1.0 | 0.5 |
| Kokubo (c-SBF) | 142.0 | 5.0 | 2.5 | 1.5 | 4.2 | 147.8 | 1.0 | 0.5 |
Publisher’s Note: MDPI stays neutral with regard to jurisdictional claims in published maps and institutional affiliations. |
© 2022 by the authors. Licensee MDPI, Basel, Switzerland. This article is an open access article distributed under the terms and conditions of the Creative Commons Attribution (CC BY) license (https://creativecommons.org/licenses/by/4.0/).
Share and Cite
Zhao, J.; Haowei, M.; Saberi, A.; Heydari, Z.; Baltatu, M.S. Carbon Nanotube (CNT) Encapsulated Magnesium-Based Nanocomposites to Improve Mechanical, Degradation and Antibacterial Performances for Biomedical Device Applications. Coatings 2022, 12, 1589. https://doi.org/10.3390/coatings12101589
Zhao J, Haowei M, Saberi A, Heydari Z, Baltatu MS. Carbon Nanotube (CNT) Encapsulated Magnesium-Based Nanocomposites to Improve Mechanical, Degradation and Antibacterial Performances for Biomedical Device Applications. Coatings. 2022; 12(10):1589. https://doi.org/10.3390/coatings12101589
Chicago/Turabian StyleZhao, Jinguo, Ma Haowei, Abbas Saberi, Zahra Heydari, and Madalina Simona Baltatu. 2022. "Carbon Nanotube (CNT) Encapsulated Magnesium-Based Nanocomposites to Improve Mechanical, Degradation and Antibacterial Performances for Biomedical Device Applications" Coatings 12, no. 10: 1589. https://doi.org/10.3390/coatings12101589
APA StyleZhao, J., Haowei, M., Saberi, A., Heydari, Z., & Baltatu, M. S. (2022). Carbon Nanotube (CNT) Encapsulated Magnesium-Based Nanocomposites to Improve Mechanical, Degradation and Antibacterial Performances for Biomedical Device Applications. Coatings, 12(10), 1589. https://doi.org/10.3390/coatings12101589

